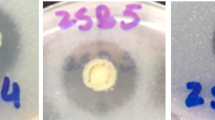

Abstract
The effects of genotypes (HD3086 and PBW343) and soil physicochemical properties on the wheat rhizospheric bacterial communities along the trans Indo-Gangetic plains were studied. The trans-Indo-Gangetic Plains of India are one of the areas in the country where wheat is grown the most. Despite the agricultural significance of this region, extensive studies on the rhizosphere microbial abundance and community structure related to wheat cultivation in this area are still lacking. To address this knowledge gap, the present study was undertaken to characterize the rhizosphere microbiome using full-length 16 S rRNA–based metagenomic profiling, implementing universal primers, tailed with PacBio Sequel II barcode sequences, providing new insights into microbial dynamics across this major wheat-producing landscape. Statistical analysis revealed significant differences in both abundance and diversity among the different soil samples and wheat genotypes. Four phyla exhibited significant differences in relative abundance between the genotypes (p < 0.05): Proteobacteria (p = 0.002), Planctomycetes (p = 0.000), Verrucomicrobia (p = 0.000), and Firmicutes (p = 0.030). The number of genera identified in genotype HD3086 across all locations was 421, while it was 322 for genotype PBW343. There were 251 genera found common, with 170 genera exclusively present in HD3086 and 71 in PBW343. Significant differences were observed in the relative abundance of eighteen genera (p < 0.05) between the genotypes; some of them include Luteolibacter, Gemmata, Pseudomonas, Stenotrophobacter, Pseudarthrobacter, Devosia, Lacibacter, Gaiella, Luteimonas, and Nitrosospira. Correlation analysis indicated significant associations between microbial diversity and soil parameters like pH, total and available nitrogen, potassium, phosphorus, iron, and organic carbon for both varieties. Core taxa analysis revealed 27 core taxa across both genotypes. The study highlights significant genotype effects on rhizosphere microbiomes, with implications for soil health and crop management strategies.
Similar content being viewed by others
Data availability
The sequence data generated was submitted to NCBI database with project number (Project number: PRJNA1128054; SRA ID: SRR29548375 to SRR29548382).
References
Arora, N. K., Fatima, T., Mishra, I. & Verma, S. Microbe-based inoculants: role in next green revolution. In Environmental Concerns and Sustainable Development (eds Shukla, V. & Kumar, N.) 191–246 (Springer, Singapore, 2020).
Durán, P. et al. Screening and characterization of potentially suppressive soils against Gaeumannomyces Graminis under extensive wheat cropping by Chilean Indigenous communities. Front. Microbiol. 8 https://doi.org/10.3389/fmicb.2017.01552 (2017).
Žiarovská, J., Medo, J., Kyseľ, M., Zamiešková, L. & Kačániová, M. Endophytic bacterial Microbiome diversity in early developmental stage plant tissues of wheat varieties. Plants 9 https://doi.org/10.3390/plants9020266 (2020).
Dilla-Ermita, C. J., Lewis, R. W., Sullivan, T. S. & Hulbert, S. H. Wheat genotype-specific recruitment of rhizosphere bacterial microbiota under controlled environments. Front. Plant. Sci. 12 https://doi.org/10.3389/fpls.2021.718264 (2021).
Abdullaeva, Y. et al. Domestication impacts the wheat-associated microbiota and the rhizosphere colonization by seed- and soil-originated microbiomes, across different fields. Front. Plant. Sci. 12. https://doi.org/10.3389/fpls.2021.806915 (2022).
Bender, S. F., Wagg, C. & van der Heijden, M. G. An underground revolution: biodiversity and soil ecological engineering for agricultural sustainability. Trends Ecol. Evol. 31 https://doi.org/10.1016/j.tree.2016.02.016 (2016).
Mahoney, A. K., Yin, C. & Hulbert, S. H. Community structure, species variation, and potential functions of rhizosphere-associated bacteria of different winter wheat (Triticum aestivum) cultivars. Front. Plant. Sci. https://doi.org/10.3389/fpls.2017.00132 (2017).
Fan, K. et al. Rhizosphere-associated bacterial network structure and Spatial distribution differ significantly from bulk soil in wheat crop fields. Soil. Biol. Biochem. 113 https://doi.org/10.1016/j.soilbio.2017.06.020 (2017).
Burns, J. H., Anacker, B. L., Strauss, S. Y. & Burke, D. J. Soil microbial community variation correlates most strongly with plant species identity, followed by soil chemistry, Spatial location and plant genus. AoB Plants. 7 https://doi.org/10.1093/aobpla/plv030 (2015).
Sergaki, C., Lagunas, B., Lidbury, I., Gifford, M. L. & Schäfer, P. Challenges and approaches in Microbiome research: from fundamental to applied. Front. Plant. Sci. 9. https://doi.org/10.3389/fpls.2018.01205 (2018).
Zhalnina, K. et al. Dynamic root exudate chemistry and microbial substrate preferences drive patterns in rhizosphere microbial community assembly. Nat. Microbiol. 3 https://doi.org/10.1038/s41564-018-0129-3 (2018).
Zheng, Y. et al. Core root-associated prokaryotic community and its relationship to host traits across wheat varieties. J. Exp. Bot. 74. https://doi.org/10.1093/jxb/erad066 (2023).
Toju, H. et al. Core microbiomes for sustainable agroecosystems. Nat. Plants. 4 https://doi.org/10.1038/s41477-018-0139-4 (2018).
Busby, P. E. et al. Research priorities for Harnessing plant microbiomes in sustainable agriculture. PLoS Biol. 15. https://doi.org/10.1371/journal.pbio.2001793 (2017).
Lemanceau, P., Blouin, M., Müller, D. & Moënne-Loccoz, Y. Let the core microbiota be functional. Trends Plant. Sci. 22 https://doi.org/10.1016/j.tplants.2017.04.008 (2017).
Zheng, Y. et al. Wheat-root associated prokaryotic community: interplay between plant selection and location. Plant. Soil. 464 https://doi.org/10.1007/s11104-021-04945-6 (2021).
Martin-Laurent, F. et al. DNA extraction from soils: old bias for new microbial diversity analysis methods appl. Environ. Microbiol. 67. https://doi.org/10.1128/AEM.67.5.2354-2359.2001 (2001).
Oliveros, J. C. Venny. An interactive tool for comparing lists with Venn’s diagrams (2015). Available at: http://bioinfogp.cnb.csic.es/tools/venny/
Metsalu, T. & Vilo, J. ClustVis: a web tool for visualizing clustering of multivariate data using Principal Component Analysis and heatmap. Nucleic acids Res. 43 https://doi.org/10.1093/nar/gkv468. (2015).
Cappelli, S. L., Domeignoz-Horta, L. A., Loaiza, V. & Laine, A. L. Plant biodiversity promotes sustainable agriculture directly and via belowground effects. Trends Plant. Sci. 27 https://doi.org/10.1016/j.tplants.2022.02.003 (2022).
Suman, A. et al. Microbial community and function-based synthetic bioinoculants: a perspective for sustainable agriculture. Front. Microbiol. 12 https://doi.org/10.3389/fmicb.2021.805498 (2022).
Acuña, J. J. et al. Diversity, community structure, and potential functions of root-associated bacterial communities of different wheat (Triticum aestivum) cultivars under field conditions. Agronomy 13 https://doi.org/10.3390/agronomy13051392 (2023).
Berg, G. & Smalla, K. Plant species and soil type cooperatively shape the structure and function of microbial communities in the rhizosphere. FEMS Microbiol. Ecol. 68. https://doi.org/10.1111/j.1574-6941.2009.00654.x (2009).
Walters, W. A. et al. Large-scale replicated field study of maize rhizosphere identifies heritable microbes. Proc. Natl. Acad. Sci. 115 https://doi.org/10.1073/pnas.1800918115 (2018).
Simonin, M. et al. Influence of plant genotype and soil on the wheat rhizosphere Microbiome: evidences for a core Microbiome across eight African and European soils. FEMS microbiol. Ecol 96 https://doi.org/10.1093/femsec/fiaa067 (2020).
Donn, S., Kirkegaard, J. A., Perera, G., Richardson, A. E. & Watt, M. Evolution of bacterial communities in the wheat crop rhizosphere. Environ. Microbiol. 17 https://doi.org/10.1111/1462-2920.12452 (2015).
Yin, C. et al. Bacterial communities on wheat grown under long-term conventional tillage and no-till in the Pacific Northwest of the united States. Phytobiomes 1 https://doi.org/10.1094/PBIOMES-09-16-0008-R (2017).
Kumar, M. et al. Core microbiota of wheat rhizosphere under upper indo-gangetic plains and their response to soil physicochemical properties. Front. Plant. Sci. 14. https://doi.org/10.3389/fpls.2023.1186162 (2023).
Ansari, W. A. et al. Influence of rice-wheat and sugarcane-wheat rotations on microbial diversity and plant growth promoting bacteria: insights from high-throughput sequencing and soil analysis. Microbiol. Res. 278. https://doi.org/10.1016/j.micres.2023.127533 (2024).
Zhang, X., Liu, S., Jiang, Z., Wu, Y. & Huang, X. Gradient of microbial communities around seagrass roots was mediated by sediment grain size. Ecosphere 13 https://doi.org/10.1007/s10.1002/ecs2.3942 (2022).
Astorga-Eló, M. et al. Composition, predicted functions and co-occurrence networks of rhizobacterial communities impacting flowering desert events in the Atacama desert. Chile Front. Microbiol. 11. https://doi.org/10.3389/fmicb.2020.00571 (2020).
Jiang, C., Sun, X. R., Feng, J., Zhu, S. F. & Shui, W. Metagenomic analysis reveals the different characteristics of microbial communities inside and outside the Karsttiankeng. BMC Microbiol. 22 https://doi.org/10.1186/s12866-022-02513-1 (2022).
Bziuk, N. et al. Tillage shapes the soil and rhizosphere Microbiome of barley-but not its susceptibility towards Blumeria Graminis f. sp. hordei. FEMS microbiol. Ecol 97 https://doi.org/10.1093/femsec/fiab018 (2021).
Dhondge, H. V. et al. Exploring the core microbiota in scented rice (Oryza sativa L.) rhizosphere through metagenomics approach. Microbiol. Res. 263. https://doi.org/10.1016/j.micres.2022.127157 (2022).
Xu, T. et al. Characterization of the microbial communities in wheat tissues and rhizosphere soil caused by Dwarf bunt of wheat. Sci. Rep. 11. https://doi.org/10.1038/s41598-021-85281-8 (2021).
Pérez-Jaramillo, J. E., Mendes, R. & Raaijmakers, J. M. Impact of plant domestication on rhizosphere Microbiome assembly and functions. Plant. Mol. Biol. 90 https://doi.org/10.1007/s11103-015-0337-7 (2016).
Rascovan, N. et al. Integrated analysis of root microbiomes of soybean and wheat from agricultural fields. Sci. Rep. 6 https://doi.org/10.1038/srep28084 (2016).
Wu, A. L. et al. Effect of continuous sorghum cropping on the rhizosphere microbial community and the role of Bacillus amyloliquefaciens in altering the microbial composition. Plant. Growth Regul. 89 https://doi.org/10.1007/s10725-019-00533-y (2019).
Wu, T., Qin, Y. & Li, M. Intercropping of tea (Camellia sinensis l.) and Chinese chestnut: variation in the structure of rhizosphere bacterial communities. J. Soil. Sci. Plant. Nutr. 21. https://doi.org/10.1007/s42729-021-00513-0 (2021).
Lang, M., Christie, P., Zhang, J. & Li, X. Long-term phosphorus application to a maize monoculture influences the soil microbial community and its feedback effects on maize seedling biomass. Appl. Soil. Ecol. 128. https://doi.org/10.1016/j.apsoil.2018.01.005 (2018).
Zhuang, W. et al. Diversity, function and assembly of Mangrove root-associated microbial communities at a continuous fine-scale. Biofilms Microbiomes. 6 https://doi.org/10.1038/s41522-020-00164-6 (2020).
Wang, C. et al. Integrated organic and inorganic fertilization and reduced irrigation altered prokaryotic microbial community and diversity in different compartments of wheat root zone contributing to improved nitrogen uptake and wheat yield. Sci. Total Environ. 842. https://doi.org/10.1016/j.scitotenv.2022.156952 (2022).
Hamonts, K. et al. Field study reveals core plant microbiota and relative importance of their drivers. Environ. Microbiol. 20. https://doi.org/10.1111/1462-2920.14031 (2018).
Chen, T. et al. Soil bacterial community in the multiple cropping system increased grain yield within 40 cultivation years. Front. Plant. Sci. 12. https://doi.org/10.3389/fpls.2021.804527 (2021).
Xia, F. et al. Effect of salt stress on Microbiome structure and diversity in chamomile (Matricaria Chamomilla L.) rhizosphere soil. Agronomy 13 https://doi.org/10.3390/agronomy13061444 (2023).
Luo, Y. et al. Complete genome sequence of Sphingomonas sp. Cra20, a drought resistant and plant growth promoting rhizobacteria. Genomics 112 https://doi.org/10.1016/j.ygeno.2020.04.013 (2020).
Yu, M. et al. Bacterial community structure and putative nitrogen-cycling functional traits along a charosphere gradient under waterlogged conditions. Soil. Biol. Biochem. 162 https://doi.org/10.1016/j.soilbio.2021.108420 (2021).
Banerjee, S., Schlaeppi, K. & van der Heijden, M. G. Keystone taxa as drivers of Microbiome structure and functioning. Nat. Rev. Microbiol. 16 https://doi.org/10.1038/s41579-018-0024-1 (2018).
Dai, Y. et al. Wheat-associated microbiota and their correlation with Stripe rust reaction. J. Appl. Microbiol. 128. https://doi.org/10.1111/jam.14486 (2020).
Morales, M. E. et al. Rhizospheric Microbiome responses to cover crop suppression methods. Agronomy 12 https://doi.org/10.3390/agronomy12102246 (2022).
McDonald, M. D., Lewis, K. L., Blazier, J. C. & Gentry, T. J. Semi-arid soil bacterial communities are refined by altered plant selection pressure under conservation management practices. Appl. Soil. Ecol. 194. https://doi.org/10.1016/j.apsoil.2023.105191 (2024).
Muwawa, E. M. et al. 16S rRNA gene amplicon-based metagenomic analysis of bacterial communities in the rhizospheres of selected Mangrove species from mida creek and Gazi Bay, Kenya. PLoS One. 16 https://doi.org/10.1371/journal.pone.0248485 (2021).
Acknowledgements
The authors are highly thankful to Centre for Agricultural Bioinformatics (CABin), and Network Project on Agricultural Bioinformatics and Computational Biology under which fund has been received from Indian Council of Agricultural Research (ICAR). Authors also express gratitude to the Director, ICAR-National Bureau of Agriculturally Important Microorganisms, Mau, India, for infrastructure facilities.
Funding
Network Project on Agricultural Bioinformatics and Computational Biology, Indian Council of Agricultural Research.
Author information
Authors and Affiliations
Contributions
MK: Conceptualization, Supervision, Writing - review & editing. WAA: Soil sampling, Investigation, Formal analysis, Visualization, Writing - original draft. ASi: Formal analysis, Writing - review & editing. HC: Writing - review & editing. SCK and MTZ: Soil biochemical analysis. MSF, AS, SS, and GKJ: did statistical analysis, bioinformatics analysis, and interpretation of the data. AKS: Resources, Writing - review & editing.
Corresponding author
Ethics declarations
Ethics approval and consent to participate
Not applicable.
Consent for publication
Not applicable.
Competing interests
The authors declare no competing interests.
Additional information
Publisher’s note
Springer Nature remains neutral with regard to jurisdictional claims in published maps and institutional affiliations.
Supplementary Information
Below is the link to the electronic supplementary material.
Rights and permissions
Open Access This article is licensed under a Creative Commons Attribution-NonCommercial-NoDerivatives 4.0 International License, which permits any non-commercial use, sharing, distribution and reproduction in any medium or format, as long as you give appropriate credit to the original author(s) and the source, provide a link to the Creative Commons licence, and indicate if you modified the licensed material. You do not have permission under this licence to share adapted material derived from this article or parts of it. The images or other third party material in this article are included in the article’s Creative Commons licence, unless indicated otherwise in a credit line to the material. If material is not included in the article’s Creative Commons licence and your intended use is not permitted by statutory regulation or exceeds the permitted use, you will need to obtain permission directly from the copyright holder. To view a copy of this licence, visit http://creativecommons.org/licenses/by-nc-nd/4.0/.
About this article
Cite this article
Kumar, M., Ansari, W.A., Singh, A. et al. Impact of genotype and soil fertility on wheat rhizosphere microbiota under the trans-gangetic plain. Sci Rep (2026). https://doi.org/10.1038/s41598-026-36646-4
Received:
Accepted:
Published:
DOI: https://doi.org/10.1038/s41598-026-36646-4